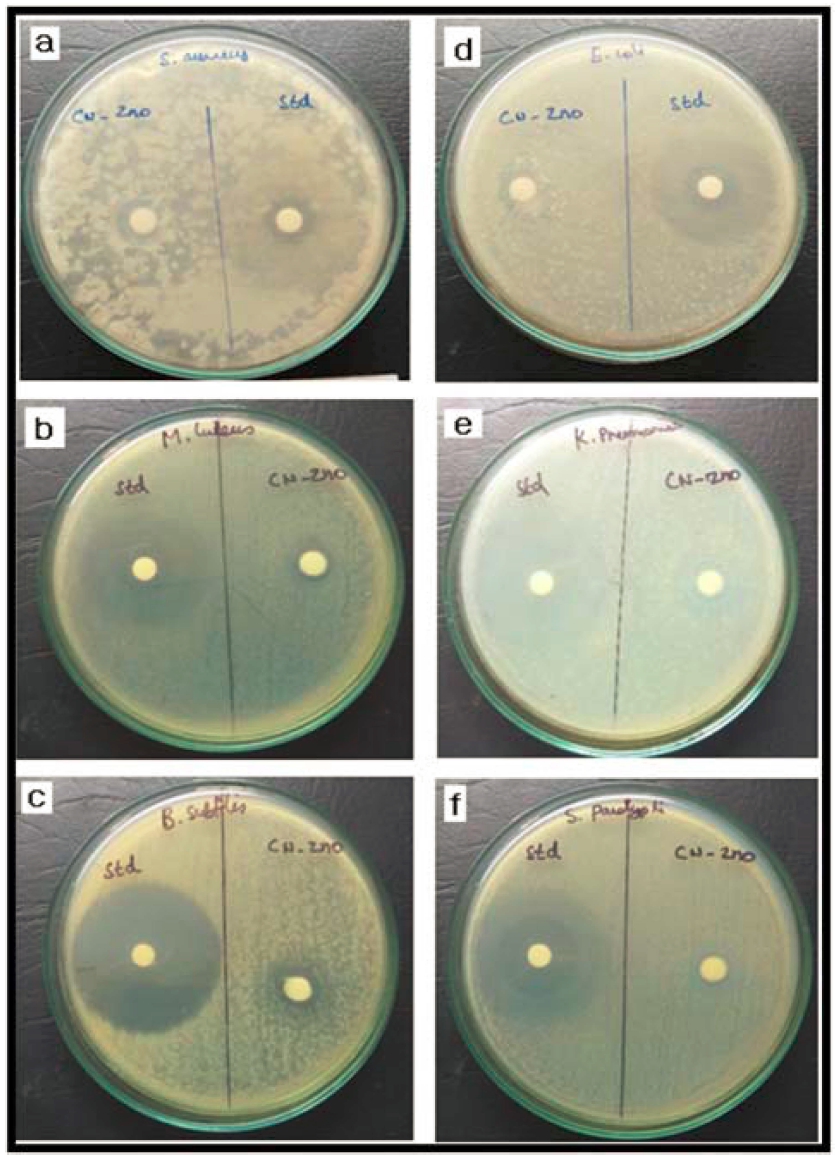
https://cdn.apub.kr/journalsite/sites/mrsk/2020-030-05/N0340300506/images/MRSK-30-5-252_F10.jpg

1. 서 론
최근에 환경 문제가 증가함에 따라 화학 합성법 대신 에 새로운 친환경 방법으로 식물 추출물을 사용하여 나 노입자를 합성하는 방법에 대한 연구가 바이오, 화학 및 재료공학 분야에서 활발히 진행되고 있다.1-3) 환경 친화 적인 방법으로 나노입자를 합성하는 방법은 합성과정에 서 독성 화학 물질을 사용하지 않는 장점이 있으며, 이 러한 측면에서 환경 친화적인 방법을 기반으로 한 합성 방법은 산업적으로 요구되는 나노 입자를 얻기 위한 새 로운 방법들을 제공한다.
Cyathea nilgiriensis는 인도 남부에 서식하는 나무 고 사리이다.4) 시아테아(Cyathea) 속에 속하는 나무 고사리 는 241종의 종(種)과 4종의 잡종이 산악 지대에 분포되 어 있다.5) 인도에는 Cyathea nilgiriensis 나무 고사리처 럼 멸종 위기에 처해있는 11종의 Cyathea가 있으며, 야 생 동식물에 관한 CITES(멸종 위기 종의 국제 무역 협 약) 부록 II에도 수록되어 있다.6)Cyathea nilgiriensis 나 무 고사리는 Kerala, Karnataka, Tamil Nadu 및 Andhra Pradesh 지역에서 그늘지고 습기가 많은 시내 쪽 숲의 일부에만 분포한다.7)Cyathea nilgiriensis 나무 고사리는 진통 효과가 있기 때문에 인도에서 뱀에 물린 상처을 치 료하는 민간 요법으로 널리 사용된다.8) 또 다른 Cyathea gigantea 줄기는 항염 작용을 하며, Cyathea crinita(Hook) Copel의 뿌리줄기와 sporophyll은 항 박테리아 성질을 가 진 것으로 알려져 있다.9-11)
다양한 금속 산화물 중에서 ZnO는 새로운 생물학적 기 능과 독특한 특성 때문에 유용하고 가치 있는 물질 중 하나이다. ZnO 산화물의 나노 구조는 항 곰팡이,12) 항 박테리아,13) 항 바이러스,14) 상처 치유,15) 자외선 필터링 특성, 높은 촉매 및 광화학 활성, 우수한 안정성 및 생 체 적합성을 나타내어 많은 연구자들의 관심 대상이 되 고 있다. 최근 몇 년 동안 다양한 유형의 식물 추출물 이 나노 결정질 물질의 합성에서 환원제 또는 캡핑제로 사용되는 것으로 보고되었으며, 본 연구진은 Pongamia pinnata, Nerium oleander, 알로에 잎 및 Vitex negundo L 잎 추출물을 사용하여 ZnO 나노 입자를 친환경적으로 합성하고 그 결과를 전문 학술지에 다수 발표하였다.16-19) 본 연구 결과에 따르면 식물 추출물에 존재하는 생체 분 자는 효율적인 캡핑제로서 작용하여 나노 입자 합성에 서 중추적이고 다양한 역할을 한다. 캡핑제는 정전기적 안정화, 입체 안정화, 수화력에 의한 안정화, 공핍 안정 화 및 반데르발스 힘을 이용한 안정화를 포함하는 다양 한 메커니즘에 의해 나노 입자를 안정화시킨다. 식물 및 기타 천연 자원은 구조적으로 복잡하고 다양한 화합물 의 형태를 제공하기 때문에 많은 연구자들이 식물 및 미 생물의 추출물, 순수 2차 대사 산물 및 새로운 합성 분 자들을 잠재적인 항균제로 연구하는 데 집중 해왔다.20-22) 금속 나노 입자의 항 박테리아 및 세포 독성 효과에 대 한 많은 보고23-24)가 있지만, 식물 추출물을 사용하여 제 조한 금속 산화물 나노 입자에 대한 연구결과는 거의 없 다. 따라서 식물 추출물을 이용한 ZnO 나노 입자의 녹 색 합성과 생체 의학 분야에서 응용에 초점을 맞추어 연 구를 수행하였으며, 본 연구에서는 Cyathea nilgiriensis 식물 추출물을 사용하여 친환경 합성방법으로 ZnO 나 노 입자를 제조하여 분말의 구조 및 특성을 분석하고 항 균성을 평가하였다.
2. 실험방법
Cyathea nilgiriensis 나무고사리 잎을 수집하여 흐르는 물로 완전히 씻은 다음 작은 조각으로 절단하고 건조시 키기 위하여 50 °C의 순환 오븐에 두었다. 건조된 잎 약 10 g을 증류수와 혼합하여 10분간 끓였으며, 2회 반복하 였다. 혼합물은 여과지(Whatman No.1)를 사용하여 여과 하여 밝은 갈색의 추출물을 얻었고, 여과액은 250 mL 삼 각 플라스크에 수집하였다. 또한 GC-MS 분석을 위해, 20 g의 잎 분말을 Soxhlet 장치를 사용하여 250 mL의 에 탄올 용매로 8시간(78.2 °C) 추출 하였으며, 얻어진 식물 잎 추출물을 증류 농축 하여 GC-MS 분석을 하였다.
ZnO 나노 입자을 합성하기 위하여 0.1M의 Zn(NO3)2· 6H2O 수용액 50 mL와 Cyathea nilgiriensis 잎 추출물 10 mL를 혼합하여 80 °C에서 2시간 교반하여 수산화 질 산 아연 침전물을 형성시켰다. 수산화 질산 아연 침전 물 혼합액을 10,000 rpm에서 10분간 원심 분리하여 수 산화 질산 아연 침전물을 얻었다. 이어서, 원심 분리된 복합체를 물로 세척하고 다시 5,000 rpm에서 10분간 원 심 분리하였다. 분리된 복합체를 40 °C의 오븐에서 8시 간 건조 후, 전기로(muffle furnace)을 이용하여 450 °C 에서 하소하여 ZnO 나노 입자를 얻었다.
합성된 ZnO 나노분말의 XRD 분석은 PANalytical’s X-ray diffractometer 장비를 이용하였으며, Cu Kα를 사 용하여 40 kV에서 30 mA로 10 ~ 80° 범위에서 측정하였 다. FTIR 분석은 500 ~ 4,000 cm−1 범위의 Nicolet 520P FT-IR 분광계를 사용하여 분석하였으며, 입자 크기 분석 기(Nanophox, Sympatec, Germany)를 사용하여 크기 분 포를 측정하였다. SEM 분석은 JEONL JSM 6390 장비 를 이용하였으며, TEM 분석에는 CM 200(Philips, USA) 장비를 사용하였다.
ZnO 나노분말의 항균활성을 분석하고자 디스크 확산 방법을 이용하여 3 g 그람 양성균(S. aureus, B. subtilis 및 M. luteus)과 3 g 그람 음성균(E. coli, S. paratyphi 및 K. pneumonia)에 대해 시험하였고, 유사하게 항진균 분석은 C. albicans와 A. niger의 두 균주에 대해 시험 하였다.
3. 결과 및 고찰
3.1 합성한 ZnO 나노분말의 형태, 크기 및 구조
본 연구에서는 처음으로 Cyathea nilgiriensis 식물 추 출물을 사용하여 환경 친화적 인 새로운 합성방법으로 ZnO 나노 입자를 합성하였다. ZnO 나노 입자 합성에 사 용된 Cyathea nilgiriensis 식물 추출물에서 화합물을 분 석하여 그 결과를 Table 1에 나타내었다. Table 1에서 보여 주는 바와 같이 15종류의 화합물 분석결과 13종류 의 화합물이 존재하는 것으로 분석되었다. 플라보노이드, 테르페노이드, 트리 테르페노이드, 폴리페놀 및 글리코시 드와 같은 대사산물은 더 높은 농도로 나타났으며(++로 표시), 타닌, 사포닌, 스테로이드, 알칼로이드, 탄수화물, 단 백질, 안트라퀴논 및 쿠마린과 같은 대사산물은 약간 낮 은 농도로 존재하며(+로 표시), 플로바탄닌과 안토시아닌 대사산물은 검출되지 않았다.
Janakiraman et al. 연구진25)에 따르면 3.12분에서 38.75분까지 GC-MS 분석을 통하여 Cyathea nilgiriensis 에 존재하는 식물 속 화합물의 주성분은 메틸옥타데실 디클로로실란(C19H40Cl2Si) 29.19 %와 2-Methylbutane-1, 4-diol,3-1-ethoxyethoxy(C9H20O4) 24.48 %로 구성되어 있다. Janakiraman et al. 연구진의 실험방법에 기반하여 본 연구에서는 분석 시간을 1시간(60분)으로 변경하여 60 개의 화학물질을 예측하였다.
Fig. 1은 Cyathea nilgiriensis 식물 추출물의 GC-MS 스펙트럼을 나타낸다. GC-MS 분석에서 분석시간 1시간 동안 60개의 화합물을 예측하였다. 60개의 화합물 중 7 개의 화합물이 피크 영역 1 % 이내에 존재하고 있으 며, 나머지 53개의 화합물 중 43개의 화합물이 1 ~ 5 % 의 피크 영역 내에 존재한다. 나머지 10종류 중 6종류 1-Hexadecene(C16H32), 테트라데칸산 에틸 에스테르 (C16H32O2), 옥타데칸산 에틸 에스테르(C20H40O2), 2,2,4,4- tetrakis(t-butyl)-1,3-bis[(mesityl)mercurio]-1,3-diphospha– 2,4-disiletane(C34H58Hg2P2Si2), Heptadecanoic acid-15- methyl-ethylester(C20H40O2) 및 1,2-bis(Trimethylsilyl)-4- (t-butyl)-1-bromo-2,2-bi phenyl(C26H33BrSi2) 등은 5 ~ 10 % 범위에 속하는 화합물이다. 이들 화합물에 대한 NIST 데이터와 분석된 피크가 일치할 확률은 각각 7.39 %, 76.54 %, 79.26 %, 36.74 %, 12.27 % 및 24.7 %이다. 따라서 테트데칸산 에틸 에스테르와 옥타데칸산 에틸 에 스테르 화합물이 주요 화합물로 여겨진다. 나머지 4개의 화합물, 즉 C18H36O2 화합물, C21H54F2N2OSi5 화합물, C19H38N4O10 화합물 및 C25H39NO11 화합물은 10 ~ 15 % 범위에 존재하며, NIST 데이터와 일치 할 확률은 각각 74.17 %, 18.66 %, 14.29 % 및 10.66 %이고, 헥사데칸산 에틸 에스테르(C18H36O2)가 주요 화합물이다. C18H13BrO 및 C14H7Cl3O5 화합물 같은 플라보노이드는 환경친화적인 합성에 관여하는 화합물이다. Fig. 2는 Cyathea nilgiriensis 식물추출물의 주요 화합물인 에스테르, 플라보노이드 및 페놀 화합물의 화학 구조 및 분자식을 보여준다.
Fig. 3은 Cyathea nilgiriensis 식물 추출물을 사용하여 합성한 ZnO 나노 입자의 FT-IR 스펙트럼을 나타낸다. FT-IR 스펙트럼 분석은 Cyathea nilgiriensis 식물 추출 물에 의해 합성된 ZnO 나노 입자의 캡핑 및 안정화에 기여하는 생체 분자를 찾기 위하여 시험하였다. 그림에 서 보는 바와 같이 ZnO 나노 입자의 FT-IR 스펙트럼 은 418 ~ 555 cm−1에서 흡수된다. O-H 스트레치는 3,373 cm−1부터 매우 넓은 대역에서 나타난다. 넓은 대역의 OH 스트레치 밴드는 C=O 피크와 함께 나타나며, 화합물 이 지방족 카복실산임을 나타낸다. 1,112 cm−1에서의 CF에 기인 한 2개의 피크는 모노 및 폴리 플루오르화 화 합물을 나타낸다. 1,590 ~ 1,468 cm−1 영역의 중간 흡수 는 방향족 고리의 존재를 의미한다. 1,047 cm−1의 흡수 피크는 포화된 알콜의 C-O 스트레치를 나타내고, 2,927 cm−1에서 눈에 띄는 이중 복사 흡수는 방향족 알데히드 의 C-H 신축 진동이며, 1,690 cm−1의 밴드는 플라보노 이드의 카보닐 그룹을 나타낸다.
Fig. 4는 Cyathea nilgiriensis 식물 추출물의 FT-IR 스 펙트럼을 나타낸다. 그림에서 보는 바와 같이 O-H 은 3,428 cm−1에 나타난다. 2,072.44 cm−1에서 포스핀(phosphine) 의 존재를 보여 주며, 16,432 및 1,532 cm−1에서 primary amine(NH2) 및 아미드(N-H) 스트레칭 진동을 나타낸다. 알콜 및 페놀릭 O-H 밴드 그룹은 1,349 cm−1의 범위로 나타난다. 마지막으로, 알킨 C-H 변형은 632 ~ 680 cm−1 에서 보여준다. FT-IR 결과 잎으로부터 추출된 트리테르 페노이드, 스테롤, 알콜, 탄화수소, 플라보노이드, 쿠마 린, 탄닌, 탄수화물, 단백질, 글리코시드와 같은 생물 미 생물들이 나노 입자에 부착된다고 여겨진다.
FT-IR 분석 결과, 플라보노이드의 페놀 화합물은 금속 과의 결합력이 강하기 때문에 페놀 기가 금속 나노 입 자를 형성하여 응집을 방지하고 그로 인해 매체를 안정 화시킬 수 있음을 나타낸다. 이것은 생물학적 분자가 수 성 매질에서 ZnO 나노 입자의 형성과 안정화의 이중 기 능을 수행 할 수 있음을 시사한다. Gnanasangeetha 등 26)은 식물 추출물 azadirachta 및 emblica에서 테르페노 이드가 ZnO 나노 입자의 형성 및 안정화에 기여한다고 하였으며, 플라보노이드는 ZnO 나노 입자의 안정화 및 캡핑에 중요한 역할을 한다고 하였다.
Fig. 5는 친환경적으로 합성된 ZnO 나노 입자의 XRD 스펙트럼을 나타내었다. 주요 피크을 나타내는 2θ값은 31.70, 34.38, 36.20, 47.52, 56.54, 62.85, 67.95 및 69.05이다. 스펙트럼의 위치는 (1 0 0), (0 0 2), (1 0 1), (1 0 2), (1 0 0), (1 0 3) 및 (2 0 1)면을 나타내어 ZnO 육방구조임을 보여준다(표준 JCPDS 카드 79-2205). (1 0 1)면으로부터 계산된 평균 결정립 크기는 29.11 nm 이었다. 이 연구에서 얻은 XRD 패턴은 생물학적으로 합 성된 ZnO 나노 입자에서 얻어진 XRD 패턴과 유사하 며,27) 화학적 합성방법은 이전에 보고되었다.28) Yedurkar 등29)은 Ixora coccinea 잎 추출물에서 관찰한 ZnO 나노 입자는 구형이며 크기가 80 ~ 130 nm이고, Raut 등30)은 Ocimum tenuiflorum 잎 추출물에서 11 ~ 25 nm의 크기 를 갖는 육방구조의 나노 입자를 제안했다.
Fig. 6(a) ~ (c)는 합성된 ZnO 나노 입자의 SEM 이미 지을 보여준다. 그림에서 보는 바와 같이 ZnO 나노입 자는 응집된 형태를 나타낸다. 응집된 덩어리를 자세히 살펴보면 많은 나노 입자의 응집체가 존재함을 알 수 있 다. Fig. 6(a)에서 입자는 응집되어 나타나고 개별 결정 의 일부가 선명하게 보이며, Fig. 6(b)에서 덩어리는 길 쭉한 육각형의 혈소판 형태를 나타낸다. Fig. 6(c)에서 나 타낸 바와 같이 육각형 소판과 분리된 나노 크기 입자 가 존재하는 것은 명확하다. Fig. 6(c)의 일부 입자의 크 기는 0.05 nm보다 작은 것으로 나타났으며, 이는 입자가 나노 크기로 간주 될 수 있음을 시사한다. Fig. 6(d)의 EDX 결과는 ZnO 나노 입자가 생성되었음을 나타낸다.
Fig. 7(a) ~ (d)는 TEM과 SAED 패턴으로 분석한 ZnO 나노 입자의 크기와 형태를 보여준다. Fig. 7(d)의 회절 패턴에서 보여 주듯이 ZnO 나노 입자는 육방구조를 나 타낸다. 육각형 모양의 분자가 명확하게 보이지 않는 것 은 생체 분자들이 산화 아연 입자 표면에 캡핑되어 있기 때문이다. 회절패턴은 합성된 ZnO 나노입자의 (1 0 0), (0 0 2), (1 0 1), (1 0 2), (1 0 0), (1 0 0), (1 0 3), (2 0 0), (1 1 2) 및 (2 0 1)을 나타낸다. 생체 분자는 ZnO 나노 입자의 형성에 기여하는 것으로 알려져 있으 며, TEM 분석에 나타난 입자 크기는 XRD 분석 결과 와 잘 일치한다.
입자의 평균 크기와 합성된 ZnO 나노 입자의 크기 분 포를 분석하여 그 결과를 Fig. 8에 나타내었다. 그림에 서 보는 바와 같이 ZnO 나노 입자의 입자 크기는 20 ~ 40 nm의 크기 분포를 나타내며, 이러한 결과는 SEM 분 석에서 측정된 30 nm의 평균 입자 크기와 잘 일치함을 나타낸다.
Cyathea nilgiriensis 식물 추출물에서 합성한 ZnO 나노 분말 형성기구를 Fig. 9에 나타내었다. Cyathea nilgiriensis 식물 추출물의 예비 분석 결과 알칼로이드, 테르페노이 드, 플라보노이드, 페놀 및 스테로이드의 존재가 확인되 었다.31) 이들 대사 산물은 수성 추출물을 고도로 산화시 키는 역할을 하며 ZnO 나노 입자의 생물학적 환원에 중 요한 역할을 한다. 플라보노이드는 안토시아닌, 이소 플 라보노이드, 플라보놀, 칼콘, 플라본 및 플라바논을 포함 하는 폴리페놀 화합물 군이다. 금속 이온 감소는 플라 보노이드에서 카복실산으로의 케톤 전환의 내부 메카니 즘에 기인한다. 또한 일부 플라보노이드는 Fe2+, Fe3+, Cu2+, Zn2+, Al3+, Cr3+, Pb2+ 및 CO2+와 같은 금속 이온을 카르보닐기 또는 p- 전자로 킬레이트하는 것으로 알려져 있다.32) 또한, Cyathea nilgiriensis 식물 추출물에 존재하 는 플라보노이드, 테르페노이드 및 페놀기와 같은 수용 성 화합물의 작용기는 나노 입자의 합성 및 안정화에 관 여하는 것으로 보인다. 이전 연구에서 생물학적 물질에 존재하는 단백질 또는 다당류가 나노 입자를 캡핑하고 안정화시키는 것으로 보고 했다.33-34) Johnson과 그 연구 진은35)Cyathea nilgiriensis 추출물에서 플라보노이드의 존재로 인한 Ag 이온의 감소와 Ag 나노 입자의 안정 화를 보고 했다. 이 과정에서 전구체로 선택되는 질산 아 연은 아연-아르세테린 복합체와 같은 금속 킬레이트 복합 체를 형성하기 위해 플라보노이드 아르세텔린과 반응한 다. 그런 다음 복합체 용액을 8시간 동안 오븐에서 유지 시켜 수산화물 복합체를 얻는다. 최종적으로 수산화물 복 합체를 450 °C에서 하소하여 안정한 금속 산화물 나노 입 자를 형성하며, 이 반응에서 플라보노이드는 C14H7Cl3O5 화합물이며, arthothelin으로 알려져 있다. C14H7Cl3O5 화 합물은 trihydorxy 플라보노이드 화합물이므로 쉽게 금속 을 받아들여 복합체를 형성한다. 본 연구에서 ZnO 나 노 입자의 FT-IR 결과는 플라보노이드의 수산기와 카르 보닐기의 존재가 있음을 시사한다. 또한, Johnson과 그 연구진은35) 금속에서 Ag 나노 입자의 합성에 관여하는 플라보노이드의 존재를 제시하였다.
3.2 ZnO 나노분말의 항균 활성
박테리아 및 곰팡이에 대한 ZnO 나노 입자의 항균 활 성은 입자 크기, 분말 농도, 형태, 비표면적 등에 따라 달 라진다. Stan 등은36) 부추속 사디움, 로즈마리 Officinalis, Ocimum basilicum 등의 식물 추출물 항균 활성을 설명 했다. 그들의 결과에 따르면 ZnO 나노 입자는 황색 포 도상구균(S. aureus), 고초균(B. subtilis), 리스테리아균(L. monocytogenes), 대장균(E. coli), 살모레나균(S. typhimurium) 및 녹용균(P. aeruginosa) 박테리아 균주에 대해 우수한 살 균 활성을 보였다. 본 연구에서는 Cyathea nilgiriensis 식물 추출물에서 얻은 바이오 합성 ZnO 나노 입자의 항균 효 율을 분석 하였다.
Fig. 10은 Cyathea nilgiriensis 식물 추출물에서 바이 오 합성으로 얻은 ZnO 나노 입자의 항균 이미지를 나 타낸다. 3종류의 그람 양성 세균(포도상구균, 고초균 및 마이크로코커스 루테우스균) 및 3종류의 그람 음성 세균 (대장균, 살모레나균 및 페렴구균)에 대한 항균 활성을 나 타내었으며, 시프로플록사신은 모든 박테리아 균주의 표 준이다. Table 2는 ZnO 나노 입자의 저지 영역을 나타 내었으며, 곰팡이 및 세균 균주 모두에 대해 100g/디스 크 샘플을 채취하여 분석하였다. 3종류의 그램 양성 세 균에 대한 표준 시프로플록사신 억제 영역은 포도당구 균 32 mm, 고초균 40 mm 및 마이크로코커스 루테우스 균 34 mm로 측정되었다. 3종류의 그람 양성 세균 중 고 초균(16 mm)의 저해 구역이 포도당구균(32 mm)과 마이 크로코커스 루테우스균(34 mm) 보다 더 높았다. 3종류의 그람 음성 박테리아에 대한 표준 시프로플록사신 저해 구역은 대장균 36 mm, 살모레나균 36 mm 및 페렴균 38 mm로 측정되어 페렴구균이 다른 음성 박테리아 균주와 비교하여 더 높은 억제 영역을 나타내었다.
Fig. 10
Antibacterial images of ZnO nanoparticles [a-c] S. aureus, M. luteus & B. subtilis (Gram positive bacterias) [d-f] E. coli, K. pneumoniae & S. paratyphi (Gram negative bacterias).
생합성 된 ZnO 나노 입자의 영역 억제는 표면 산소 종의 생성 속도가 세포막 파괴의 중요한 역할을 하며 결 국 병원균의 사멸을 초래한다. 억제 영역은 병원체의 유 형, 합성 방법 및 ZnO 나노 입자의 농도에 따라 다르 게 나타난다. W. Rizwan과 그 연구진은37) ZnO 나노 입 자 디스크의 농도를 증가시킴으로써 한천 배지에서 나 노 입자의 적절한 확산으로 인해 성장 억제가 지속적으 로 증가한다는 것을 발견했다. 박테리아의 기공 크기 보 다 작은 나노 입자는 방해 없이 세포막을 가로 지르며 충격을 주었다.38) 또한 표면에 주로 나타나는 금속 산화 물 나노 입자의 항균 활성은 세포벽에 존재하는 단백질 의 티올(-SH) 그룹과 결합한다. 이러한 상호 작용은 세 포 용해를 감소시켜 세포 융합을 유도하며,39) 세포막의 손상은 미네랄, 단백질 및 유전 물질의 누출로 이어져 세포 사멸을 초래한다.
Table 3은 생합성 ZnO 나노 입자의 항진균 결과를 나 타내었으며, Fig. 10은 두 가지 균주에 대한 ZnO 나노 입자의 곰팡이 방지 이미지를 보여준다. Table 3에서 보 는 바와 같이 2종류 곰팡이 종에 대한 표준 클로 트리 마졸에 대한 억제 구역은 칸디다 알비칸스균 37 mm와 아스페르길루스 니게르균 30 mm로 측정되었으며, 칸디다 알비칸스균(15 mm)은 다른 균류 인 아스페르길루스 니 게르균(11 mm)에 비해 더 높은 억제 구역을 나타낸다. 항균 활성은 미생물에서 음전하를 띤 세포막과 양전하 를 띤 나노 입자 사이의 정전 기 인력, 아연을 포함한 금속 이온과 미생물 및 ZnO 배열의 상호 작용을 통해 유도되며, 바이오 합성법을 사용하여 합성된 ZnO 나노 입자는 시험된 균류에 대해 우수한 항진균 활성을 갖는 것으로 밝혀졌다. Cyathea nilgiriensis 식물 추출물을 사 용하여 생합성화된 ZnO의 항균 작용은 세균 뿐만 아니 라 곰팡이 종에도 좋은 결과를 나타내었다. 따라서 나 노 입자는 잠재적인 항진균제로서 사용될 수 있으며, 기 존의 살균제에 대한 내성을 극복하는 대안으로 주목 받 으며, 곰팡이 질병 관리의 장애물을 극복하는 것을 도 울 수 있을 것으로 기대된다.
4. 결 론
Cyathea nilgiriensis 식물 추출물을 이용하여 ZnO 나 노분말을 합성하여 다음과 같은 결론을 얻었다.
1. GC-MS 분석은 식물 Cyathea nilgiriensis의 에탄올 추출물에서 다양한 식물 화학 성 분의 존재를 확인하였다.
2. Cyathea nilgiriensis 식물 추출물을 이용한 ZnO 나 노 입자 합성은 침전제 및 캡핑 제를 사용하여 실온에 서 수산화물 침전, 450 °C에서 하소를 통한 녹색 화학 공정 에 의해 얻어졌다.
3. 생합성 된 ZnO 나노 분말은 육방구조을 나타내며, 평균 결정립 크기는 29.11 nm로 측정되었다.
4. 생합성 된 ZnO 나노 입자는 그람 음성균과 그람 양성균에 대해 우수한 항 박테리아 활성을 나타내었으 며, 칸디다 알비칸스균은 다른 균류 인 아스페르길루스 니게르균 에 비해 우수한 항진균 작용을 보였다.
5. 생합성 된 ZnO 나노 입자는 박테리아 및 곰팡이 식물 병원균에 대해 우수한 멸균특 성을 나타내어 농업 분야의 상업적 응용을 위한 항균제에 사용될 수 있음을 시사한 다.
















